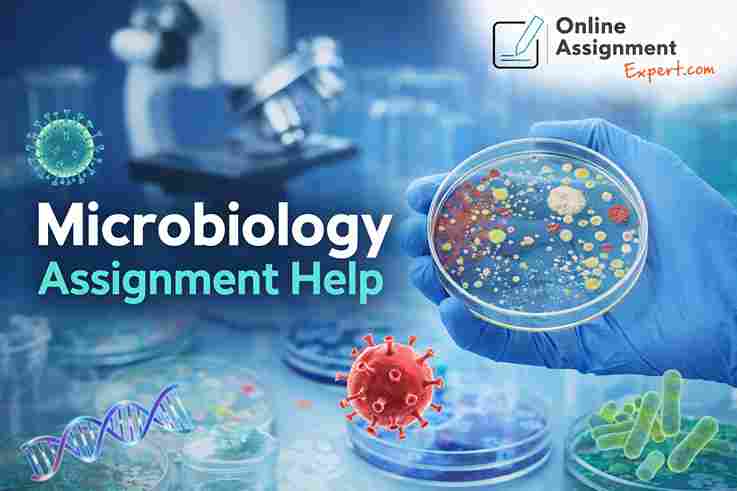

Facing challenges with complex microbiology concepts and deadlines? Get professional academic support from experienced experts who deliver accurate and plagiarism-free assignments tailored to your requirements. Our services cover topics like bacteriology, virology, immunology, and lab reports with proper referencing styles. With our Microbiology Assignment Help, students can improve their understanding and achieve better grades without stress. We ensure timely delivery, affordable pricing, and 24/7 assistance to meet your urgent needs. Take advantage of this limited-time discount and boost your academic performance with reliable, high-quality assignment solutions designed for success.
Company/Business name: Online Assignment Expert
Street Address: Level 50, 120 Collins Street, CBD (Central Business District), Melbourne, VIC 3000,
Postal/Zip Code: 1848
Email: kaylejames45@gmail.com
Phone: 480015851
Share Ad: